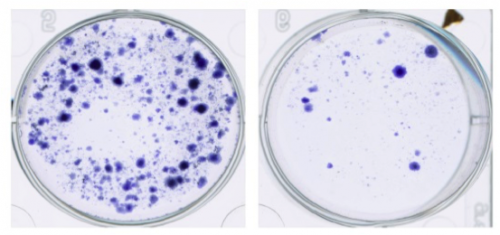

1. Platz Region Mainz: myPOP/p42POP
PD Dr. Luise Florin, Dr. Elena Wüstenhagen, Dr. Marc Schneider
MYPOP ist ein fast unbekanntes menschliches Protein, das in allen bisher getesteten humanen Zellen vorkommt. Handelt es sich jedoch um eine Krebszelle –egal welchen Ursprungs - ist MYPOP stark reduziert oder fehlt gänzlich. Wenn MYPOP allerdings wieder in die Tumorzelleneingebracht wird, verlangsamt sich die Teilungsrate der Zellen und sie sterben schließlich ab. Damit ist MYPOP nicht nur ein neuer Tumormarker, sondern ein neuer Angriffspunkt der Krebstherapie. Die neu aufgedeckte proliferations- und expressionsregulierende Wirkung von MYPOP kann außerdem industriell (z. B.: bei der Erzeugung von Biopharmazeutika) genutzt werden.
1. Platz
2019
Region Mainz